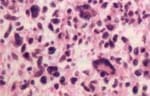
Aspecto histológico de glioblastoma Aspecto histológico de glioblastoma

Dra. Susana Murcia de Onatra
Unidad de Patología Pediátrica
Departamento de Patología
Facultad de Medicina Universidad
Nacional Hospital de la Misericordia
Santa Fe de Bogotá
Historia Clínica
Niño de 5 años, natural y procedente de Casanare traído por la abuela.
Su enfermedad se inicia con irritabilidad, cambios de comportamiento, “lo notan más retraído”,. A los diez días es llevado al médico de la localidad quien encuentra inyección conjuntival, desconexión con el medio, disartria, lateropulsión derecha, conmisura labial desviada a la izquierda, rigidez cervical y lo remite.
Antecedentes
Producto de parto gemelar de segunda gestación, el otro gemelo falleció a los15 días no sabe la causa. Peso y tallas desconocidas. Amigdalitis a repetición, vacunas completas, resto de antecedentes negativos. Vive en la cabecera municipal, convive con 5 personas, agua de acueducto rural y hay gatos, gallinas y perros. La informante niega contacto con roedores.
Examen de Ingreso
Peso 20 k Talla 96 cm, FC 90 x min Fr 18 x min Temp 36OC. Mal estado general, decaído, inyección conjuntival, secreción ocular bilateral amarillenta, obnubilado, disártrico, no colabora para valoración de equilibrio y marcha, estrabismo convergente, pupilas reactivas a la luz, desviación de conmisura labial a la izquierda, hipotonía, rigidez nucal, reflejos tendinosos ++, cardiopulmonar normal, abdomen blando sin megalias.
Se realiza Tac y se interpreta inicialmente como edema y colapso ventricular por lo cual no se realiza punción lumbar El C hemático muestra Hto 41%, Hb 13.6 g/dl, Blancos 10100, N 33%, Linfos 47,% M 4%, Eos 15%, plaquetas 370.000. El Ionograma muestra Na 149 meq/l. Cl 127,meq/l, y la química sanguínea, glicemia 90 mg/dl, transaminasas, BUN y creatinina normales, Gotas gruesas (tres) negativas. Se inicia cloranfenicol y penicilina cristalina en dosis meníngeas.
Entre el segundo y el tercer día continúa irritable, con periodos de somnolencia y letargia, lenguaje incoherente; el fondo de ojo papila pálida y se encuentra paresia de IV, VI, VII central derechos; fuerza 5/5. Se añade aciclovir y dexametasona. Se revisa TAC y se observa además obstrucción parcial del IV ventrículo, aumento de la cisterna magna y alteración en la relación sustancia gris y blanca y se decide iniciar tratamiento anti TBC ya que se encuentra además dato de que el padre es tosedor crónico.
Entre el 4º y el 6º días continua irritable, hace hemiparesia derecha con leve hiperreflexia, retirada al estímulo doloroso en hemicuerpo izquierdo, nistagmus bilateral, rigidez cervical, no obedece órdenes sencillas, presenta hiponatremia de 114, hiperpotasemia de 7,7 Cloro de 102, Na urinario 62 mmol/ L, K urinario 50 mmol/ L, FENA 155 . Se considera que está presentando secreción inadecuada de hormona antidiurértica , Se traslada a UCI y se ordena DAD más Natrol.
Entre el 7º y el 12º días presenta F.C. 170 x´ TA 108/69, picos febriles, poliuria, endotropía izquierda, anisocoria con midriasis derecha, tendencia a movimientos de descerebración de predominio derecho, Babinsky derecho; los gases arteriales muestran alcalosis metabólica. El parcial de orina es normal. y se deja con reposición del 50% de la diuresis cada 6 horas.
Entre los días 13º y 19º se toma RNM cerebral que muestra extenso compromiso periventricular con lesiones ocupando espacio a nivel de pedúnculo cerebeloso superior izquierdo, con desplazamiento del IV ventrículo y alteraciones periven-triculares sugestivas de TBC. Continúa con fiebre, leve ictericia, bilirrubinas 2.2, TGO 122U TGP 98U, se disminuye la dosis del tratamiento anti TBC por posible toxicidad hepática.
Los Ac antihistoplasma son negativos, el látex para criptococo da positivo en dilución 1:16, y los Ag. de criptococo en orina positivos 1:16. Se sugiere Criptococcus neoformans y se inicia Anfotericina B y se espera nuevo perfil hepático para adicionar fluconazol.
Entre los días 20 y 26, fiebre de 39 – 40º C. hipertonía, acidosis metabólica compensada, requiere reposición de bicarbonato. Las transaminasas están normales, se inicia fluconazol y se suspenden antibióticos por completar esquema.
El día 31 se realiza craniectomía de fosa posterior para biopsia de lesiones de ángulo pontocerebeloso izquierdo, gastrostomía y traqueostomía. continúa con hipernatremia y poliuria.
Entre los días 32 y 35, con el resultado de la biopsia, que mostraba lesión tumoral constituida por células gliales, fusiformes, y células gigantes multinucleadas, gran proliferación vascular y necrosis y la negatividad de la tinta china para criptococo, se suspende tratamiento anti TBC y antimicótico, continúa hipotenso, en acidosis respiratoria con pupilas de 4 milímetros, sin respuesta a la luz, oculocefalógiros negativos, ruidos cardíacos bradicárdicos, hipotérmico y fallece.
Diagnósticos Clínicos Finales
Tumor de fosa posterior .Secreción inadecuada de hormona antidiurética. Acidosis respiratoria
Hallazgos de Autopsia
Se encuentra un paciente eutrófico con anisocoria con pupila derecha de 8 mm e izquierda de 5 mm, atelectasia pulmonar y algunas áreas de neumatosis intestinal.
El encéfalo muestra en la fosa posterior un tumor friable pardo, que comprometía todo el ángulo ponto-cerebeloso bilateralmente y que se extendía al cerebelo desde el tronco cerebral a través de pedúnculo cerebeloso medio figuras 1 y 2. El estudio histológico corresponde a un tumor maligno de origen glial con patrón fusocelular, con células gigantes bizarras, necrosis extensa y gran vascularización (figura No 3).
Diagnósticos Definitivos
1. Glioblastoma de células gigantes del tronco cerebral. Con compromiso de ambos ángulos ponto-cerebelosos y cerebelo
2. Atelectasia pulmonar
3. Neumatosis intestinal
![]() |
![]() |
| Figura No. 1 Fosa posterior con la lesión tumoral que es extiende a la meninge, ángulo ponto cerebeloso izquierdo, borrando la definición del tronco cerebral | Figura No. 2 x cortes del puente y cerebelo con lesión infiltrante que se extiende al pedúnculo cerebeloso izquierdo |
Figura No.3 Microfotografía: del aspecto histológico de glioblastoma de células gigantes h y e 250x
Comentario
La rápida evolución del cuadro clínico y el compromiso basal con lesión de pares y rigidez cervical, hicieron pensar que este paciente tenía un proceso infeccioso meningoencefalítico de origen tuberculoso o micótico, más si se tiene en cuenta la posible historia familia del padre tosedor crónico. La neoplasia encontrada corresponde a un tumor agresivo de la fosa posterior, de origen glial, de la variedad glioblastoma de células gigantes, que explica el rápido deterioro neurológico del niño.
Los tumores cerebrales en los niños ocupan el tercer lugar en frecuencia después de las leucemias y los linfomas. Son más frecuentes en fosa posterior y sus variedades más frecuentes son meduloblastoma (neuroectodérmico primitivo), con pico de mayor incidencia al rededor de los 5 años, ependimoma con predominio en pacientes entre 0 y 4 años y astrocitomas sólidos o quísticos de células fibrilares, con mayor incidencia alrededor de los 13 años1.
Los tumores del tronco cerebral son gliomas que afectan predominantemente pacientes entre los 5 y los 10 años, y solo en un 20% afectan a pacientes adultos. Algunos tumores se extienden hacia el diencéfalo y otros son exofíticos, comprometiendo la meninge y dirigiéndose hacia el cerebelo. A través de los pedunculos cerebelosos.
El compromiso de largos tractos y de pares craneanos es causa de grande y progresiva disabilidad y mortalidad; la sobrevida global es del 15 al 30% a 10 años1. Su pronóstico es peor si la lesión compromete pares craneanos o si se extiende a la medula espinal, si la evolución del cuadro clínico es muy rápida y si el paciente es de muy corta edad2.
Histológicamente estos gliomas presentan variables grados de diferenciación, lo cual dificulta su clasificación definitiva en material de biopsias; los bien diferenciados corresponden a astrocitomas pilocíticos, gliomas mixtos, ologodendrogliomas, pero existen formas agresivas como el astrocitoma anaplásico, el glioblatoma multiforme y ocasionalmente el glioblastoma de células gigantes3, 4.
Los glioblastomas de células gigantes son más raros en esta localización, y en niños, pués predominan en los hemisferios cerebrales y en adultos hombres; son de crecimiento rápido, causan deterioro acelerado del paciente y se caracterizan por ser muy vascularizados, tener extensa necrosis; tienen además de la línea glial, células gigantes multinucleadas, bizarras y una red densa de fibras reticulínicas. Algunos pueden surgir de lesiones bien diferenciadas pero en niños pequeños se considera que la lesión es primaria. Se han encontrado mutaciones genéticas a nivel TP53 en el 90% de los casos3.
El tratamiento con radioterapia puede ofrecer algún beneficio, pero el pronóstico es malo teniendo en cuenta el aspecto histológico de alta malignidad y la localización, que hace imposible la resección quirúrgica1.
Bibliografía
1. Alvord EC, Chau ChM_ Neopasms of the Nervus System en Dukett S ed: Pediatric Neuropathology Baltimorwe Williams Wilkins 1995:684.
2. Albright AL, Guthketcch AN, Paker RJ et al :Prognostic factors in pediatric brain stem gliomas J Nerosurg 1986; 65: 751.
3. Ohgaki H, Watanabe K, Giant cell glioblastoma Pathology and genetidcs tumours of the Nervus sistemLyon international agense for research on cancer 1997;1997 16:25-6.
4. Kleinhues P, Benger PC et al : Glioblastoma. Pathology and genetidcs tumours of the Nervus sistemLyon international agense for research on cancer 1997;16: 24



